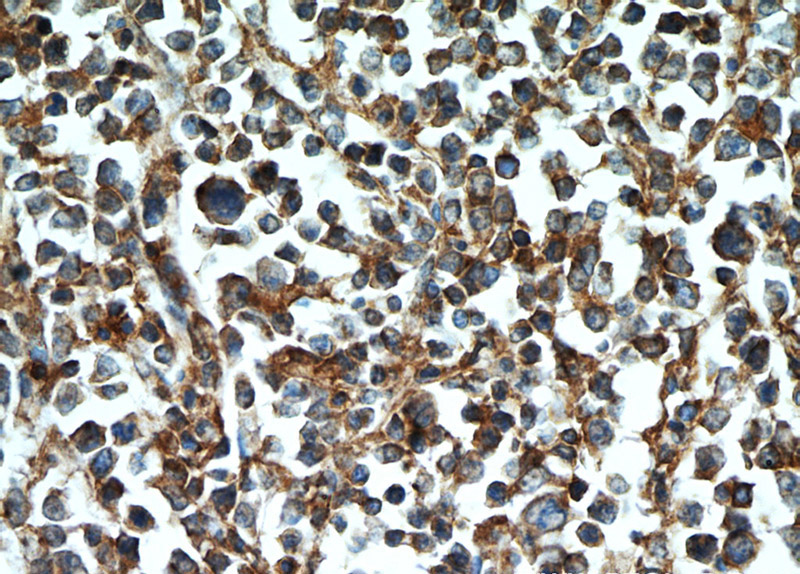
Immunohistochemical of paraffin-embedded human lymphoma using Catalog No:109125(CD45 antibody) at dilution of 1:50 (under 40x lens)

-
Product Name
CD45 antibody
- Documents
-
Description
CD45 Rabbit Polyclonal antibody. Positive WB detected in mouse liver tissue. Positive IP detected in mouse spleen tissue. Positive IHC detected in human lymphoma tissue, human tonsil tissue, human tonsillitis tissue. Positive FC detected in Jurkat cells. Observed molecular weight by Western-blot: 180-220 kDa
-
Tested applications
ELISA, IHC, WB, FC, IP
-
Species reactivity
Human, Mouse; other species not tested.
-
Alternative names
B220 antibody; CD45 antibody; CD45R antibody; GP180 antibody; L CA antibody; LCA antibody; LeukOCyte common antigen antibody; LY5 antibody; PTPRC antibody; RPTPC antibody; T200 antibody
-
Isotype
Rabbit IgG
-
Preparation
This antibody was obtained by immunization of CD45 recombinant protein (Accession Number: BC014239). Purification method: Antigen affinity purified.
-
Clonality
Polyclonal
-
Formulation
PBS with 0.1% sodium azide and 50% glycerol pH 7.3.
-
Storage instructions
Store at -20℃. DO NOT ALIQUOT
-
Applications
Recommended Dilution:
WB: 1:200-1:1000
IP: 1:200-1:1000
IHC: 1:20-1:200
-
Validations

Immunohistochemical of paraffin-embedded human lymphoma using Catalog No:109125(CD45 antibody) at dilution of 1:50 (under 10x lens)
Immunohistochemical of paraffin-embedded human lymphoma using Catalog No:109125(CD45 antibody) at dilution of 1:50 (under 40x lens)

mouse liver tissue were subjected to SDS PAGE followed by western blot with Catalog No:109125(CD45 Antibody) at dilution of 1:300

IP Result of anti-CD45 (IP:Catalog No:109125, 4ug; Detection:Catalog No:109125 1:300) with mouse spleen tissue lysate 4800ug.

1X10^6 Jurkat cells were stained with 0.5ug CD45 antibody (Catalog No:109125, red) and control antibody (blue). Fixed with 90% MeOH blocked with 3% BSA (30 min). Alexa Fluor 488-congugated AffiniPure Goat Anti-Rabbit IgG(H+L) with dilution 1:1000.
-
Background
CD45, also known as leukocyte common antigen (LCA), B220, and T200, is a 180-240 kD single chain type I membrane glycoprotein. It is a tyrosine phosphatase expressed on the plasma membrane of all hematopoietic cells, except erythrocytes and platelets. CD45 is a signaling molecule that regulates a variety of cellular processes including cell growth, differentiation, cell cycle, and oncogenic transformation. CD45 is one of the best negative selection markers for characterizing and/or isolating human mesenchymal stem cells from bone marrow and other sources. Along with the positive selection markers (such as CD29, CD44, CD90, CD105 and CD166), negative selection markers (such as CD34 and CD45) are used for MSC identification.
-
References
- Muramatsu-Kato K, Itoh H, Kohmura-Kobayashi Y. Undernourishment in utero Primes Hepatic Steatosis in Adult Mice Offspring on an Obesogenic Diet; Involvement of Endoplasmic Reticulum Stress. Scientific reports. 5:16867. 2015.
Related Products / Services
Please note: All products are "FOR RESEARCH USE ONLY AND ARE NOT INTENDED FOR DIAGNOSTIC OR THERAPEUTIC USE"
